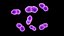
3D Enterococcus
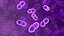
3D Enterococcus

- $ 10.000 in protezione legale (indennizzo)
- Protezione legale illimitata (indennizzo)
- Rinuncia al sollievo ingiuntivo
- Diritti di modello assegnabili
- $ 1,000,000 in protezione legale (indennizzo)
- Rinuncia al sollievo ingiuntivo
- Diritti di modello assegnabili
- $ 250.000 in protezione legale (indennizzo)
- Diritti di modello assegnabili

Human Viruses Collection 2
Human Viruses Collection 2





 Bacillus
Bacillus






